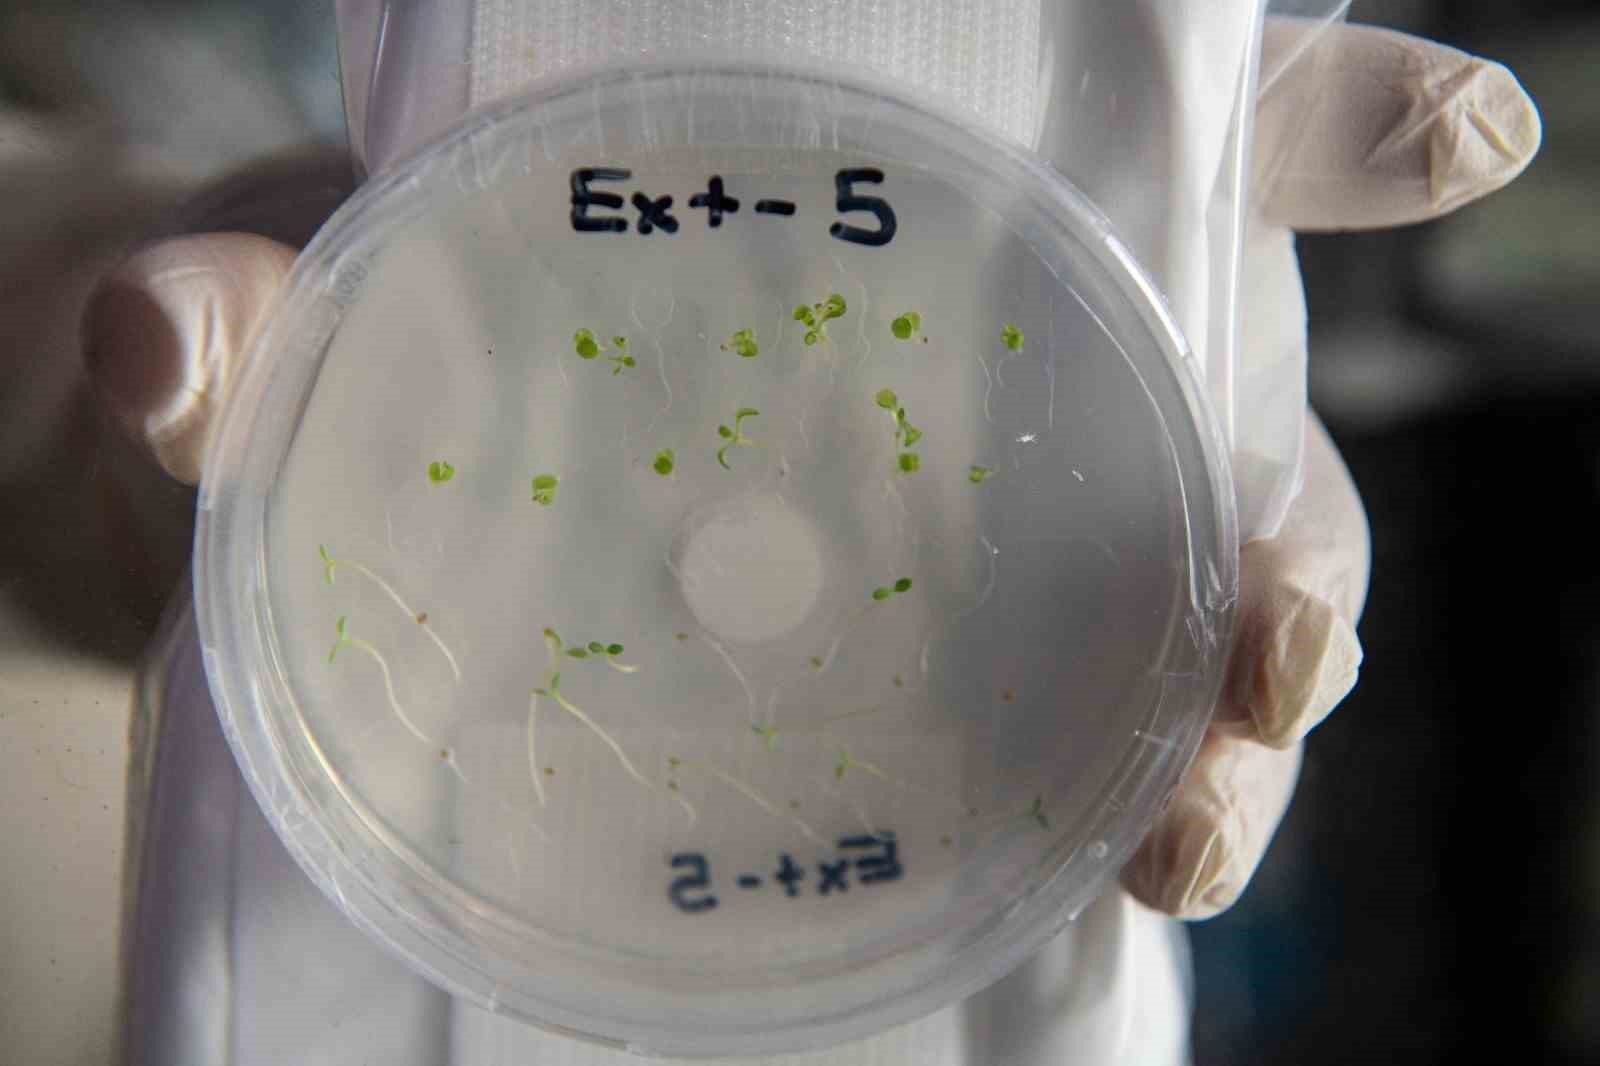

Etiket: İzmir
İlişkilerde aşk bombardımanına dikkat
MEDİCANA SAĞLIK GRUBU PSİKİYATRİ BÖLÜMÜNDEN DR. MÜGE YAŞAR, İLİŞKİNİN BAŞINDA ABARTILI İLGİ VE SEVGİNİN, BİR SÜRE SONRA AZALMASI ANLAMINA GELEN LOVE BOMBİNG; YANİ AŞK BOMBARDIMANINA DÖNÜŞTÜĞÜNÜ SÖYLEDİ.
Aliağa Petkimspor’un konuğu Fenerbahçe
ALİAĞA PETKİMSPOR, TÜRKİYE KUPASI’NDA YARIN FENERBAHÇE’Yİ KONUK EDECEK. TEK MAÇ USULÜ ÜZERİNDE OYNANACAK BU KARŞILAŞMADA KAZANAN TAKIM DÖRTLÜ FİNAL İÇİN KONYA’DA MÜCADELE ETME HAKKI KAZANACAK.
Deniz Kadah: “Futbolu bırakmayı düşündüm”
ALTAY’LA ARA TRANSFER DÖNEMİNDE YOLLARINI AYIRAN DENİZ KADAH, RESMİ SOSYAL MEDYA HESABINDAN YAPTIĞI AÇIKLAMAYLA, “AİLEMİN İÇERİSİNDE YAŞANAN SAĞLIK SORUNLARI NEDENİYLE TRANSFERİ DÜŞÜNECEK BİR DURUMDA OLMADIĞIMI VE HATTA BİR ARA FUTBOLU BIRAKMA NOKTASINA GELDİĞİMİ DE BELİRTMEK İSTERİM” İFADELERİNİ KULLANDI.
Sevgililerin çiçekleri İzmir’den: 14 Şubat öncesi hasat yoğunluğu
14 ŞUBAT SEVGİLİLER GÜNÜ ÖNCESİ ÇİÇEKÇİLER YOĞUN BİR MESAİ İLE ÇALIŞIYOR.
Göztepe’de golcü sevinci yaşanıyor
GÖZTEPE’NİN KADROSUNA KATTIĞI FORVET OYUNCUSU ROMULO CARDOSO, ÇIKTIĞI İLK MAÇINDA BANDIRMASPOR’A KARŞI 1 GOL, 1 ASİSTLE OYNAYARAK SARI-KIRMIZILI CAMİAYI MUTLU ETTİ.
Ünlü tatil merkezi Çeşme’de caddeler göle döndü
İZMİR’İN ÇEŞME İLÇESİNDE, ANİDEN BASTIRAN SAĞANAK CADDE VE SOKAKLARI GÖLE ÇEVİRDİ.
Aliağa FK, 4 hafta sonra kazandı
TFF 3. LİG 1. GRUP’TA 4 HAFTADIR ARKA ARKAYA BERABERLİK ALAN ALİAĞA FK, HAFTA SONU OYNANAN MAÇTA KARABÜK İDMANYURDU’NU MAĞLUP EDEREK 3 PUANI HANESİNE YAZDIRDI.
İnşaat ustası da artık karaborsada: 50 bin TL maaş var, eleman...
TORBALI TİCARET ODASI BAŞKANI ABDULVAHAP OLGUN, İŞÇİLERİN AYLIK ÜCRETLERİNİN 50 BİN TL'Yİ AŞTIĞINI ANCAK SEKTÖRDE ELEMAN SIKINTISI YAŞANDIĞINI SÖYLEDİ
Yılmaz Vural yönetimindeki Menemen FK, play-off hattının dışında kaldı
YILMAZ VURAL’IN TEKRAR ÇIKIŞA GEÇMEK İÇİN YOĞUN BİR ANTRENMAN PROGRAMI UYGULAYACAĞI ÖĞRENİLDİ
Gezeravcı, uzayda deney yaparken her gün görselleri Egeli ekip ile paylaştı
İLK TÜRK ASTRONOT ALPER GEZERAVCI, 21 GÜN SÜREN GÖREVİ BOYUNCA ÇEŞİTLİ ÜNİVERSİTE VE ARAŞTIRMA KURUMLARI TARAFINDAN HAZIRLANAN 13 ÖNEMLİ DENEY GERÇEKLEŞTİRDİ
Arkas Spor, Galatasaray’ı ağırlıyor
ARKAS SPOR, KUPA VOLEY ÇEYREK FİNAL MÜCADELESİNDE YARIN GALATASARAY İLE KARŞI KARŞIYA GELECEK.
Altay, 3 maç sonra kalesini gole kapattı
ALTAY, TRENDYOL 1. LİG’İN 22. HAFTA MÜCADELESİNDE ERZURUMSPOR FK İLE GOLSÜZ BERABERE KALARAK 3 MAÇLIK ARADAN SONRA KALESİNİ GOLE KAPATMAYI BAŞARDI.